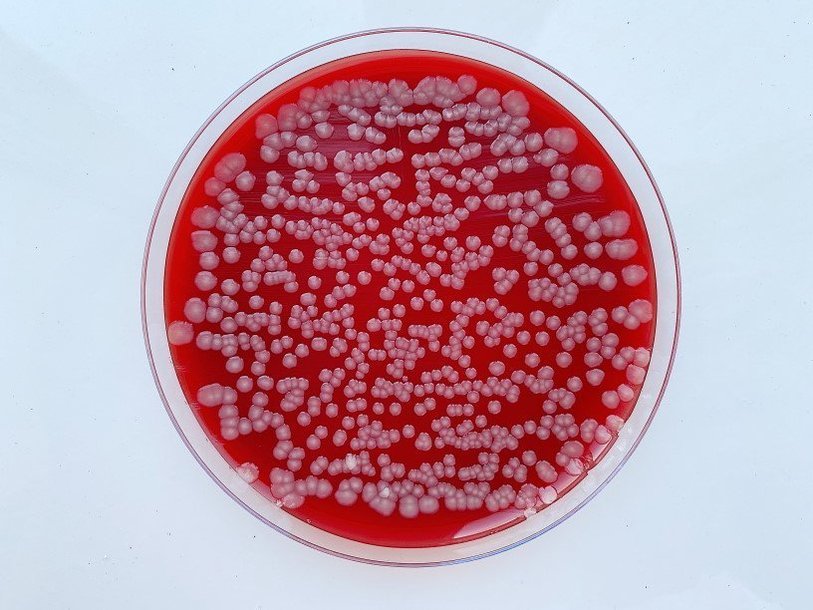

Екатерина Беленко: Промикробы: Свой среди чужих
Фото: Екатерина Беленко
Фото: Екатерина Беленко Недавно при покупке косметики мне дали пробник новой сыворотки, которая заботится не только о коже лица, но и о ее невидимых жильцах, в смысле о микробиоме кожи. Да, я прекрасно понимаю и знаю, что на нашей коже живет уйма бактерий. Да, и на лице тоже. Но даже мне кажется удивительным, что после ежедневного ритуала «умывание — тоник — сыворотка — крем — вечером-повторить» кто-то вообще выживает на коже лица. Уж уцепились так уцепились. Тем более я пока не достигла тех высот осознанности, при которых можно поддерживать микробиом лица, заботиться о добрых соседях, чтобы они не пускали злых. А еще в магазине мне попадалась на глаза зубная паста с тем же уклоном — забота о здоровой микрофлоре полости рта. Подобная мода не может не радовать, давайте все дружно заботиться о своих самых близких существах.
А пока самым опекаемым остается микробиом кишечника. Даже люди, далекие от микробиологии и медицины, переживают о последствиях приема антибиотиков. Ну, или реклама на них так действует. Заселить кишечник нужными бактериями — очень трудная задача. К сожалению, это не происходит по принципу «Что съел или выпил — тем и заселил». Главное препятствие на пути микробиков к заветным завиткам кишок — желудок. Вспоминайте восьмой класс, но не первую любовь и скомканные записочки на уроках, а курс анатомии человека. В желудке очень агрессивная среда благодаря соляной кислоте. Большинство проглоченных вами микробов падет смертью храбрых именно в желудке.
⠀
Самые стойкие бактерии прошли желудок, попали в кишечник, казалось бы, вот она, земля обетованная, но они лишь посмотрели на нее, пока транзитом добирались до унитаза. Закрепиться в кишечнике так же сложно, как и добраться до него. Поступившие с пищей полезные бактерии чаще всего незамедлительно покидают организм естественным путем. Кроме того, все подобные пробиотические препараты универсальны, а ваша микрофлора уникальна. В идеальном мире будущего будут создаваться индивидуальные сочетания бактерий, подходящие именно вам, тогда и эффективность их прикрепления и заселения возрастет.
⠀
Но есть и еще одна сторона у пробиотиковой медали. Допустим, вы (после консультации с врачом) пропили курс антибиотиков, после чего ваша микрофлора кишечника слегка вылетела в трубу. Вы решили проявить осознанность и пропили курс пробиотика. Бактерии из этого препарата выжили и закрепились в складочках кишечного эпителия. Казалось бы, все отлично, но они обустроились там, обои поклеили и не пускают вашу «оригинальную» микрофлору вернуться. Этого можно избежать, только получая дозу своей собственной микрофлоры, но это опять мечты об очень персонализированной медицине. А пока пьем кефирчик и надеемся на чудо.